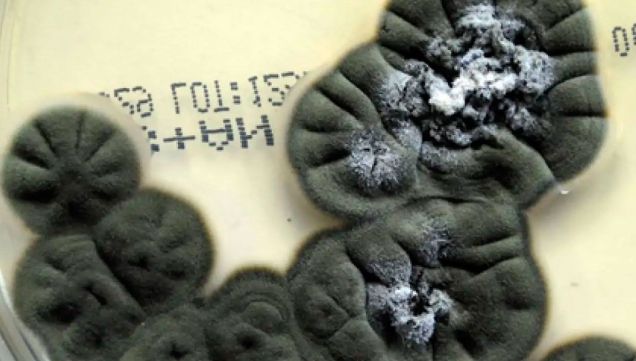

Perfil.com - Editorial Perfil S.A. | © Perfil.com 2006-2026 - Todos los derechos reservados.
Editor responsable: Carlos Piro.
Registro de la propiedad intelectual RL-2024-31002957-APN-DNDA#MJ
Dirección:
California 2715,
C1289ABI,
CABA, Argentina | Teléfono:
+54 9 11 3453 4567 | E-mail:
[email protected]